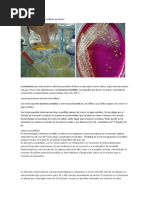

0% encontró este documento útil (0 votos)
1K vistas32 páginasAnálisis de BMA en Superficies Inertes
Este documento describe los análisis de bacterias mesofilicas aerobias, mohos y levaduras, y organismos coliformes realizados en superficies inertes de un área recreativa para menores. El objetivo es determinar qué microorganismos interactúan con los niños y pueden causar infecciones. Se resumen los métodos para identificar cada tipo de microorganismo de acuerdo a normas oficiales mexicanas.
Cargado por
Joshua Isaias MartinezDerechos de autor
© © All Rights Reserved
Nos tomamos en serio los derechos de los contenidos. Si sospechas que se trata de tu contenido, reclámalo aquí.
Formatos disponibles
Descarga como PPTX, PDF, TXT o lee en línea desde Scribd
0% encontró este documento útil (0 votos)
1K vistas32 páginasAnálisis de BMA en Superficies Inertes
Este documento describe los análisis de bacterias mesofilicas aerobias, mohos y levaduras, y organismos coliformes realizados en superficies inertes de un área recreativa para menores. El objetivo es determinar qué microorganismos interactúan con los niños y pueden causar infecciones. Se resumen los métodos para identificar cada tipo de microorganismo de acuerdo a normas oficiales mexicanas.
Cargado por
Joshua Isaias MartinezDerechos de autor
© © All Rights Reserved
Nos tomamos en serio los derechos de los contenidos. Si sospechas que se trata de tu contenido, reclámalo aquí.
Formatos disponibles
Descarga como PPTX, PDF, TXT o lee en línea desde Scribd